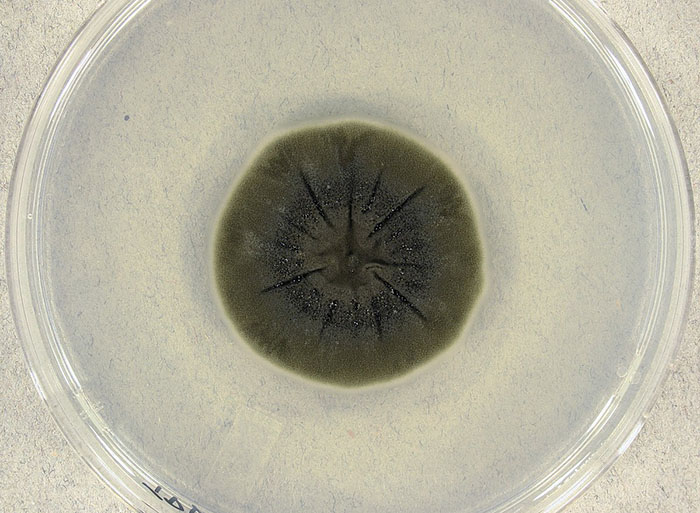

Свойства грибов изучаются для защиты людей от радиации в дальних космических полетах.
Грибы, обнаруженные на месте катастрофы Чернобыльской АЭС, были отправлены в космос в рамках исследовательского проекта, целью которого является поиск защиты людей от радиации в дальних космических полетах. Данные исследования приводит Fox News.
«Самую большую опасность для людей в миссиях по исследованию дальнего космоса представляет радиация», — объясняют ученые. По их словам, грибы, прорастающие в Чернобыле осуществляют «радиосинтез». Они поглощают радиацию и преобразуют ее в энергию.
Ученые из университета Северной Каролины в Шарлотте, Стэнфордского университета и Школы науки и математики Северной Каролины создали исследовательский проект, в котором они использовали грибы cladosporium sphaerospermum. Они отправили образец одного из таких грибов на Международную космическую станцию (МКС), где за чашкой Петри наблюдали астронавты.
«Рост cladosporium sphaerospermum и его способность ослаблять ионизирующее излучение изучались на Международной космической станции в течение 30 дней в качестве аналога обитания на поверхности Марса» — рассказали ученые в докладе.
Исследование показало, что гриб можно выращивать в космосе: «Характеристики роста также позволяют предположить, что гриб не только адаптируется, но и процветает и защищает от космической радиации в соответствии с аналогичными исследованиями на Земле».